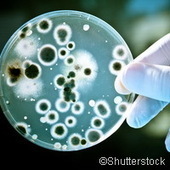

Your new post is loading...
 Your new post is loading...

|
Scooped by
Alvaro Díaz A.
December 15, 2012 5:48 AM
|
En Ojo Científico ya hemos hablado de Albert Einsten, quizás el científico más famoso de la historia, o al menos del siglo XX, y su interesante vida. La inteligencia de este hombre siempre fascinó a muchos, contemporáneos a él o a nosotros y luego de muchos años de estudios se han dado a conocer las conclusiones sobre su cerebro, que fue disecado luego de su muerte y dividido en piezas para examinarlo.

|
Scooped by
Alvaro Díaz A.
December 14, 2012 6:45 AM
|
Hace ya años que los videojuegos se han quitado el estigma de servir, únicamente, para divertirnos. Varios estudios han demostrado que no solo mejoran nuestra destreza con los dedos o hacen volar nuestra imaginación, sino que pueden llegar modular nuestro cerebro ayudándole a aprender mejor. Una reciente investigación española realizada con el videojuego El Profesor Layton ha señalado que hasta puede llegar a modificar su morfología y aumentar el volumen de materia gris cerebral.

|
Scooped by
Alvaro Díaz A.
December 14, 2012 6:11 AM
|
Esta fotografía, titulada "El observador de estrellas", ha obtenido el primer premio del concurso europeo de fotografía de vida salvaje de la Asociación Alemana de Fotógrafos de Naturaleza (GDT) en su edición de 2012. Se trata de un retrato de larga exposición dos ciervos de cola blanca comiendo durante una noche estrellada en Finlandia, captada por Vikars Tommy.

|
Scooped by
Alvaro Díaz A.
December 13, 2012 11:58 AM
|
Recipiente en el que se fabricaba el queso. El Mundo.esLos seres humanos ya eran amantes del queso hace 7.500 años.

|
Scooped by
Alvaro Díaz A.
December 13, 2012 5:15 AM
|
El investigador Adrián de Pablos, del Centro Mixto UCM-ISCIII de Investigación sobre Evolución y Comportamiento Humanos (España), ha publicado recientemente en la revista científica internacional J...

|
Suggested by
ThePinkSalmon
December 13, 2012 4:56 AM
|
A decade ago, a British philosopher put forth the notion that the universe we live in might in fact be a computer simulation run by our descendants. While that seems far-fetched, perhaps even incomprehensible, a team of physicists at the University of Washington has come up with a potential test to see if the idea holds water.

|
Suggested by
ThePinkSalmon
December 12, 2012 1:22 PM
|
Atlantis may still be a myth, but ruins of other civilizations have been discovered in oceans around the world.

|
Scooped by
Alvaro Díaz A.
December 12, 2012 7:33 AM
|
En los años 1930, el físico estadounidense Edmund Jacobson descubrió algo muy curioso cuando pedía a las personas que imaginaran que llevaban a ca...

|
Scooped by
Alvaro Díaz A.
December 12, 2012 6:38 AM
|
Ya hemos visto algunos ejemplos robóticos que nos arrojan de cabeza al Valle Inexplicable, pero en esta ocasión, el proyecto Kenshiro de la reconocida Universidad de Tokio no se enfoca tanto en una “reproducción externa” del cuerpo humano, sino...

|
Scooped by
Alvaro Díaz A.
December 11, 2012 10:43 AM
|
Un equipo de científicos se prepara para comenzar un intento de investigar un lago antiguo debajo de la capa de hielo en la Antártida.

|
Scooped by
Alvaro Díaz A.
December 11, 2012 7:50 AM
|
Una larva de insecto que vivió durante el Cretácico, hace unos 110 millones de años, y que aparece recubierta de restos vegetales, es la evidencia más antigua de camuflaje en insectos y otros invertebrados terrestres conocida hasta ahora.

|
Scooped by
Alvaro Díaz A.
December 11, 2012 6:59 AM
|
¿Quesitos de Trivial? ¡No! Las zonas horarias en la Antártida Me crucé con una página que explica una curiosidad que llevaba tiempo buscando, acerca de las zonas horarias y algunos lugares peculiares de nuestro planeta; concretamente, los polos...

|
Scooped by
Alvaro Díaz A.
December 11, 2012 6:17 AM
|
El clásico gesto de coger un tarro para embadurnarnos la piel con perfume podría caer en el olvido en un futuro no muy lejano. Al menos eso es lo que se han propuesto la artista Lucy McRae y el biólogo de la Universidad de Harvard Sheref Mansy, que juntos han desarrollado el “Swalloable Parfum”, un perfume contenido en una cápsula comestible. Tras ingerirla, la fragancia se libera a través del sudor dejando minúsculas gotas aromáticas en la piel.
|

|
Scooped by
Alvaro Díaz A.
December 14, 2012 11:46 AM
|
El 2013 revolucionará la accesibilidad de la tecnología. A pesar de que esta tecnología ya se está probando en nuestro país y de que muchos móviles ya cuentan con la capacidad para incorporar el 4G, como el Iphone 5 y el Samsung...

|
Scooped by
Alvaro Díaz A.
December 14, 2012 6:22 AM
|
Una investigación del Centro de Regulación Genómica (CRG) y el Consejo Superior de Investigaciones Científicas (CSIC) ha confirmado este jueves un modelo matemático propuesto en 1952 que podría actuar como un patrón molecular en la formación de los...

|
Scooped by
Alvaro Díaz A.
December 13, 2012 12:10 PM
|
Tejidos 'inteligentes' capaces de liberar fármacos en el lugar y el momento adecuados, medir el pH y el oxígeno del agua de forma simultánea o acortar y abaratar procesos industriales mediante la aplicación de la nanotecnología es el ámbito en el ...

|
Scooped by
Alvaro Díaz A.
December 13, 2012 5:36 AM
|
Intentar predecir el avance tecnológico de aquí a dieciocho años parece una locura. Cualquier cosa puede estar gestándose en un garaje o en los pasillos de una corporación que puede “cambiar el mundo” mañana, sólo para ser reemplazado por algo mejor un par de años después (o incluso meses). Sin embargo, el Consejo Nacional de Inteligencia de los Estados Unidos ha decidido hacer el intento con su documento “Tendencias...

|
Scooped by
Alvaro Díaz A.
December 13, 2012 5:07 AM
|
Imaginen que acuden a la consulta de su médico de cabecera, le explican sus dolencias y después de que les realice pruebas y de auscultarlos, acude a su mesa y comienza a contarle su caso particular al ordenador, que de forma completamente autónoma...

|
Scooped by
Alvaro Díaz A.
December 12, 2012 6:18 PM
|
La ciencia quiere desvelar el misterio del hombre de Piltdown. El fantástico cráneo de Piltdown se presentó el 18 de diciembre de 1912, y ahora unos científicos están analizando con técnicas avanzadas los fragmentos y los fósiles...

|
Scooped by
Alvaro Díaz A.
December 12, 2012 12:02 PM
|
Al reírse se activan los sistemas respiratorio, neurológico y cardiovascular en el organismo que desencadena un proceso que libera endorfinas facilitando la vasodilatación y reduciendo la arterioesclerosis y, en consecuencia, "es beneficiosa para...

|
Scooped by
Alvaro Díaz A.
December 12, 2012 6:59 AM
|
Investigadores europeos de la Universidad de Linköping (Suecia) han mostrado cómo ciertas bacterias utilizan un proceso denominado autoinducción para controlar distintos procesos en las células humanas. Este fenómeno consiste en una «conversación» entre bacterias mediante moléculas producidas por ellas mismas y reviste importancia durante su proliferación.

|
Scooped by
Alvaro Díaz A.
December 12, 2012 5:46 AM
|
Un nuevo video Jason Silva sobre la capacidad del cine de capturar la atención hasta el punto de que el espectador desdobla su conciencia en la narrativa que observa nos hace reflexionar sobre el poder de esta tecnología ...

|
Scooped by
Alvaro Díaz A.
December 11, 2012 10:39 AM
|
El museo científico de Vancouver Science World y la agencia Rethink Canada han realizado una campaña para mostrar al público lo divertido de la ciencia con el claim “We can explain” (nosotros lo podemos explicar) facilita ...

|
Scooped by
Alvaro Díaz A.
December 11, 2012 7:08 AM
|
Al contrario de lo que se pensaba hasta hace poco, ahora sabemos que la inteligencia se puede mejorar con la práctica. Las últimas investigaciones han revelado que ejercitando nuestro potencial de memoria y nuestra capacidad de concentración estaremos entrenando también la inteligencia.

|
Scooped by
Alvaro Díaz A.
December 11, 2012 6:32 AM
|
Investigadores australianos han reconstruido el cráneo del homo floresiensis, conocido como el 'hobbit humano', una especie de unos 18.000 años de antigüedad que fue descubierta por un equipo de arqueólogos en Indonesia, en el año 2003.
|

 Your new post is loading...
Your new post is loading...
 Your new post is loading...
Your new post is loading...